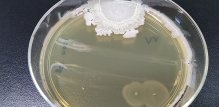
Bacillus cereus bakterija uzrokuje trovanje hranom

Bacillus cereus bakterija uzrokuje trovanje hranom
- Budite prvi i komentirajte!
- 1 min čitanja
Tekst Dana
Za vas izdvajamo
Piše psihologinja
Ljudi koji stalno kasne: Lijenost ili ozbiljan problem?
- Marija Šimunić
- 3 min čitanja
Članak objavljen: